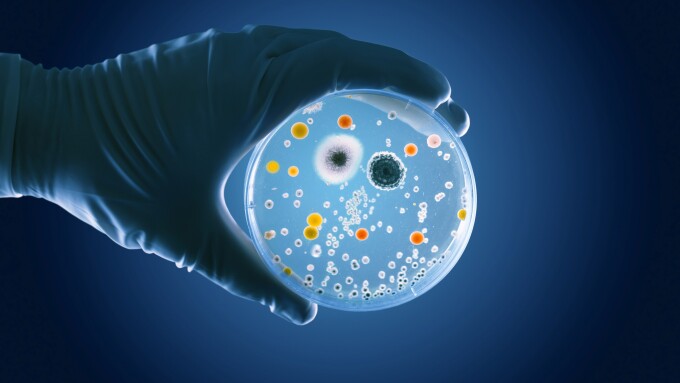
Life sciences and healthcare.jpg

Global economic changes and the impact on TP from an industry perspective
Jobst Wilmanns and Anodri Suchdeve of Deloitte Germany introduce this year’s ITR guide presenting transfer pricing insights across several industries, with analysis from Deloitte’s transfer pricing industry experts and factoring in global economic changes
-
Sponsored by DeloitteClaudia Lauten, Janis Sussick, and Karen Smolka of Deloitte discuss how amount B could impact the tax and transfer pricing approaches of global multinational enterprises in the industrial products and construction sector
-
Sponsored by DeloitteRichard Schmidtke, Heike Schenkelberg, and David Sauer of Deloitte Germany analyse the impact of specific characteristics of the life sciences and healthcare industry on the applicability of amount B
-
Sponsored by DeloitteRalf Heussner of Deloitte Japan and Aaron Lee of Deloitte Singapore examine the latest transfer pricing trends impacting the banking sector in view of the implementation of the new Basel accord from 2025
-
Sponsored by DeloitteGeoff Gill and Michael Manser of Deloitte Australia provide a guide to the upcoming public country-by-country reporting measures and how multinationals in the financial services sector should prepare for the first year of reporting
-
Sponsored by DeloitteIshan Maini of Deloitte UK and Jay Das of Deloitte US say the need for technology, media, and telecommunications companies to analyse the risks associated with intercompany transactions has never been greater
-
Sponsored by DeloitteWith ever-increasing challenges in the wholesale and retail industry, senior tax practitioners at Deloitte Germany consider the impact of amount B on the profit allocation of multinationals operating in the sector